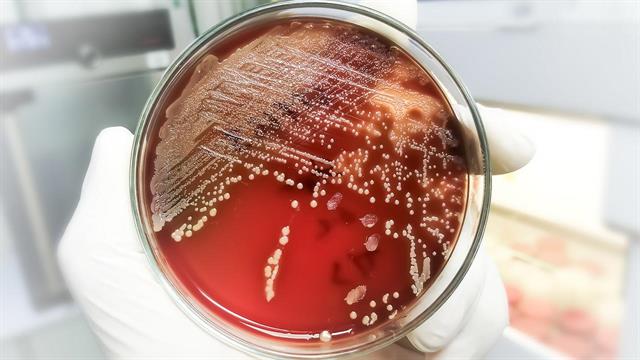
Η υπερ-κόλλα της φύσης: Οι σταφυλόκοκκοι προσκολλώνται στο δέρμα με δύναμη - ρεκόρ

Μια διεθνής ερευνητική ομάδα αποκάλυψε σε μοριακό επίπεδο γιατί οι λοιμώξεις από Staphylococcus aureus είναι τόσο δύσκολο να θεραπευτούν: τα βακτήρια χρησιμοποιούν την επιφανειακή πρωτεΐνη SdrD για να συνδεθούν με τη δεσμογλεΐνη-1 (DSG-1), μια σημαντική δομική πρωτεΐνη του ανθρώπινου δέρματος.
Σύμφωνα με τους ειδικούς, αυτή η σύνδεση είναι εξαιρετικά ισχυρή – ισχυρότερη από την υπερκόλλα και κάθε άλλη γνωστή μέχρι σήμερα φυσική πρωτεϊνική σύνδεση – και εξηγεί την ιδιαίτερη ανθεκτικότητα του παθογόνου. Τα αποτελέσματα δημοσιεύθηκαν στο "Science Advances".
"Είναι η ισχυρότερη μη ομοιοπολική σύνδεση πρωτεΐνης-πρωτεΐνης που έχει περιγραφεί ποτέ", αναφέρει ο Rafael Bernardi, αναπληρωτής καθηγητής φυσικής στο Πανεπιστήμιο Auburn και ένας από τους κύριους συγγραφείς, σε ανακοίνωση του ιδρύματός του. "Αυτό κάνει τους σταφυλόκκοκους τόσο ανθεκτικούς και μας βοηθά να κατανοήσουμε γιατί αυτές οι λοιμώξεις είναι τόσο δύσκολες να καταπολεμηθούν".
Οι ερευνητές έδειξαν ότι οι δυνάμεις σύνδεσης του SdrD με το DSG-1 φτάνουν σε τιμές άνω των 2 nanonewton – δυνάμεις που αντέχουν ακόμη και σε διαδικασίες πλύσης ή τριβής.
Το ασβέστιο παίζει βασικό ρόλο σε αυτό: "Μας εξέπληξε το πόσο πολύ συνέβαλε το ασβέστιο στη δύναμη αυτής της αλληλεπίδρασης", εξηγεί η Priscila Gomes, συν-συγγραφέας της μελέτης. "Όχι μόνο σταθεροποίησε τη βακτηριακή πρωτεΐνη, αλλά έκανε και ολόκληρο το σύμπλεγμα πολύ πιο ανθεκτικό στη θραύση."
Ισχυρός μηχανισμός προσκόλλησης στη νευροδερματίτιδα
Ο μηχανισμός έχει ιδιαίτερη σημασία για τα άτομα με ατοπική δερματίτιδα. Σε αυτά τα άτομα, η ισορροπία του ασβεστίου στο δέρμα είναι διαταραγμένη, με αποτέλεσμα το S. aureus να προσκολλάται ακόμα πιο σταθερά.
Σε εργαστηριακές δοκιμές με δείγματα δέρματος από άτομα που πάσχουν από την πάθηση, αποδείχθηκε ότι τα βακτήρια προσκολλώνται πολύ πιο ισχυρά και σε μεγαλύτερη έκταση στην επιφάνεια του δέρματος σε σύγκριση με το υγιές δέρμα.
Αυτό θα μπορούσε να εξηγήσει γιατί οι σταφυλοκοκκικές λοιμώξεις εμφανίζονται τόσο συχνά σε αυτή την ομάδα ασθενών και επιδεινώνουν την πορεία της νόσου.
Η ανακάλυψη αυτή ανοίγει νέες θεραπευτικές προοπτικές. Αντί να σκοτώνουν άμεσα τα βακτήρια – μια προσέγγιση που συχνά προάγει την αντοχή – οι μελλοντικές θεραπείες θα μπορούσαν να επικεντρωθούν στην παρεμπόδιση της προσκόλλησης. "Στοχεύοντας στην προσκόλληση, αναζητούμε έναν εντελώς νέο τρόπο καταπολέμησης των βακτηριακών λοιμώξεων", εξηγεί ο Bernardi. "Δεν προσπαθούμε να καταστρέψουμε τα βακτήρια, αλλά να τα εμποδίσουμε να προσκολληθούν".
Ωστόσο, οι συγγραφείς τονίζουν ότι τα αποτελέσματά τους βασίζονται κυρίως σε εργαστηριακές δοκιμές και υπολογιστικές προσομοιώσεις. Αν και δοκιμάστηκαν και κλινικά απομονωμένα στελέχη του S. aureus, παραμένει ανοιχτό το ερώτημα σε ποιο βαθμό τα ευρήματα μπορούν να μεταφερθούν απευθείας στους ασθενείς.
Επιπλέον, τα πειράματα διεξήχθησαν εν μέρει με Lactococcus lactis ως μοντέλο βακτηρίου. Τέλος, μελλοντικές κλινικές μελέτες θα πρέπει να δείξουν εάν η παρεμπόδιση της προσκόλλησης αποτελεί πράγματι μια αποτελεσματική θεραπευτική προσέγγιση.
Προσθέστε το iatronet.gr στο DiscoverΕιδήσεις υγείας σήμερα
Μητσοτάκης από τη Ρόδο: Νέο νοσοκομείο €45 εκατ. στην Κω
Τροφές που μπορεί να προκαλέσουν ημικρανία
Ν.Δημάσης: Γιατί πρέπει να μπει στο ''Προλαμβάνω'' ο καρκίνος του προστάτη
Θεσσαλονίκη: Καταδικάστηκε παθολόγος για τον θάνατο 17χρονου από σταφυλόκοκκο
Θεσσαλονίκη: Καταδικάστηκε παθολόγος για τον θάνατο 17χρονου από σταφυλόκοκκο Λαμία: Σταφυλόκοκκος σε δείγματα φαγητού που κατανάλωσαν μαθητές
Λαμία: Σταφυλόκοκκος σε δείγματα φαγητού που κατανάλωσαν μαθητές Νεότερο αντιβιοτικό φάνηκε αποτελεσματικό για δύσκολες λοιμώξεις στο αίμα από σταφυλόκοκκο
Νεότερο αντιβιοτικό φάνηκε αποτελεσματικό για δύσκολες λοιμώξεις στο αίμα από σταφυλόκοκκο Μα πού πρέπει να απλώσω την πετσέτα θαλάσσης μου;
Μα πού πρέπει να απλώσω την πετσέτα θαλάσσης μου; Σταφυλόκοκκος: Λοιμώξεις που προκαλεί
Σταφυλόκοκκος: Λοιμώξεις που προκαλεί Ν.Δημάσης: Γιατί πρέπει να μπει στο ''Προλαμβάνω'' ο καρκίνος του προστάτη
Ν.Δημάσης: Γιατί πρέπει να μπει στο ''Προλαμβάνω'' ο καρκίνος του προστάτη Τροφές που μπορεί να προκαλέσουν ημικρανία
Τροφές που μπορεί να προκαλέσουν ημικρανία Μητσοτάκης από τη Ρόδο: Νέο νοσοκομείο €45 εκατ. στην Κω
Μητσοτάκης από τη Ρόδο: Νέο νοσοκομείο €45 εκατ. στην Κω Πώς να χαλαρώσετε το βράδυ χωρίς αλκοόλ
Πώς να χαλαρώσετε το βράδυ χωρίς αλκοόλ Εγκαίνια 2 νέων αξονικών τομογράφων και της νέας Καρδιολογικής Κλινικής στο Γενικό Ογκολογικό Νοσοκομείο Κηφισιάς ''Οι Άγιοι Ανάργυροι''
Εγκαίνια 2 νέων αξονικών τομογράφων και της νέας Καρδιολογικής Κλινικής στο Γενικό Ογκολογικό Νοσοκομείο Κηφισιάς ''Οι Άγιοι Ανάργυροι'' 9 εξακριβωμένα οφέλη του κολοκυθόσπορου
9 εξακριβωμένα οφέλη του κολοκυθόσπορου Θεσσαλονίκη: Αγώνας ζωής για ένα μικρό θαύμα 470 γραμμαρίων
Θεσσαλονίκη: Αγώνας ζωής για ένα μικρό θαύμα 470 γραμμαρίων Χαλκιδική: Ο Μάρτιν βγήκε από τη ΜΕΘ και βρήκε τον γιατρό που τού έσωσε τη ζωή
Χαλκιδική: Ο Μάρτιν βγήκε από τη ΜΕΘ και βρήκε τον γιατρό που τού έσωσε τη ζωή ΔΕΠΥ: Πώς εμφανίζεται στις γυναίκες και γιατί συχνά αργεί η αναγνώριση
ΔΕΠΥ: Πώς εμφανίζεται στις γυναίκες και γιατί συχνά αργεί η αναγνώριση Καρπούζι: Ποια είναι τα οφέλη του στην υγεία
Καρπούζι: Ποια είναι τα οφέλη του στην υγεία CDC: Ανησυχία για ανεξέλεγκτη εξάπλωση του Έμπολα
CDC: Ανησυχία για ανεξέλεγκτη εξάπλωση του Έμπολα Η Μαριάντζελα Οικονομοπούλου αναλαμβάνει τη θέση της SEE Head of Access & External Engagement στην UCB
Η Μαριάντζελα Οικονομοπούλου αναλαμβάνει τη θέση της SEE Head of Access & External Engagement στην UCB